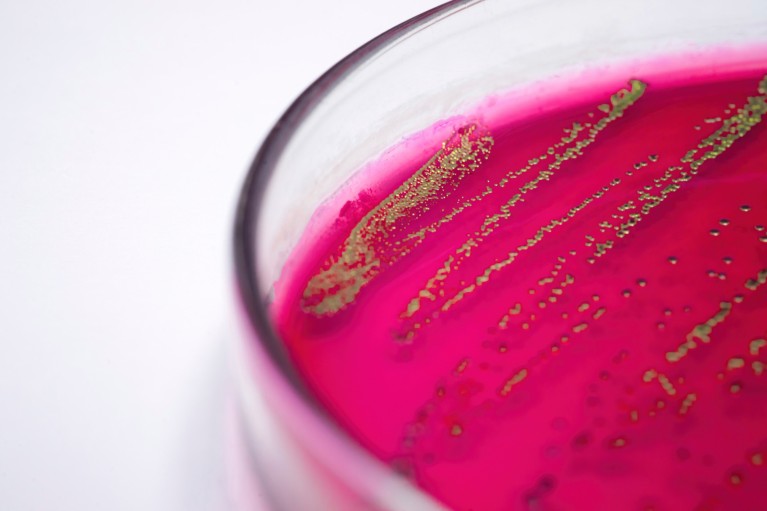
Close-up of E. coli bacteria in a petri dish

- RESEARCH HIGHLIGHT
Light-powered bacteria become living chemical factories
Escherichia coli cultures can produce compounds that aren’t found in nature when activated by light. Credit: Choksawatdikorn/Science Photo Library
Access options
Access Nature and 54 other Nature Portfolio journals
Get Nature+, our best-value online-access subscription
$32.99 / 30 days
cancel any time
Subscribe to this journal
Receive 51 print issues and online access
$199.00 per year
only $3.90 per issue
Rent or buy this article
Prices vary by article type
from$1.95
to$39.95
Prices may be subject to local taxes which are calculated during checkout
Nature 650, 10 (2026)
doi: https://doi.org/10.1038/d41586-026-00275-8
References
Yuan, Y., Li, M., Harrison, W., Zhang, Z. & Zhao, H. Nature Catal. 9, 62–72 (2026).





